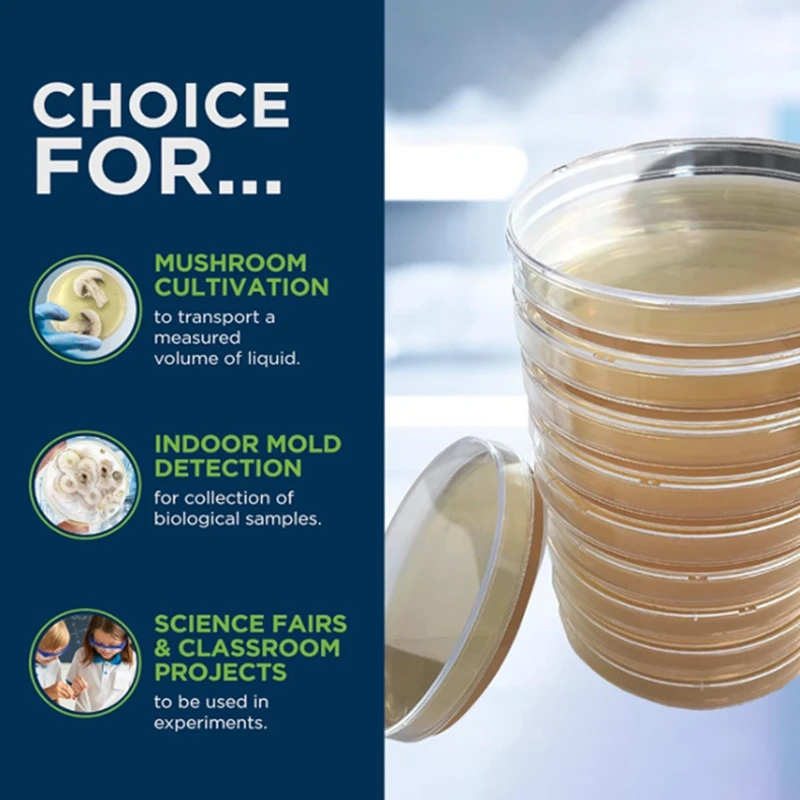

Декстроза для картофеля агар Петри бактериальная чаша грибов проект
Сохраните в закладки:






История цены
*История изменения цены! Указанная стоимость возможно, уже изменилось. Проверить текущую цену - >
| Месяц | Минимальная цена | Макс. стоимость | Цена |
|---|---|---|---|
| Sep-16-2025 | 1766.0 руб. | 1854.70 руб. | 1810 руб. |
| Aug-16-2025 | 1751.40 руб. | 1839.53 руб. | 1795 руб. |
| Jul-16-2025 | 1469.26 руб. | 1542.9 руб. | 1505.5 руб. |
| Jun-16-2025 | 1721.29 руб. | 1807.60 руб. | 1764 руб. |
| May-16-2025 | 1499.11 руб. | 1574.55 руб. | 1536.5 руб. |
| Apr-16-2025 | 1692.18 руб. | 1777.38 руб. | 1734.5 руб. |
| Mar-16-2025 | 1677.35 руб. | 1761.0 руб. | 1719 руб. |
| Feb-16-2025 | 1662.54 руб. | 1745.7 руб. | 1703.5 руб. |
| Jan-16-2025 | 1647.80 руб. | 1729.24 руб. | 1688 руб. |
Новые товары
Горячая нержавеющая сталь Французский Дом Кухня Картофель фри картофельные
",
Инструмент для удаления сердцевины фруктов из нержавеющей стали инструмент
38 ₽
Инструмент для удаления сердцевины фруктов из нержавеющей стали инструмент
45 ₽
Кухонный гаджет 1 шт. нож для ананаса из нержавеющей стали двухсторонние ананасы
",
Экологичная Овощечистка Из Нержавеющей Стали Кухонный Аксессуар Zester Для
".
Многофункциональная чеснока из нержавеющей стали для кухни приспособление
",
3 шт./компл. многофункциональная Овощечистка для ананасов из нержавеющей стали
",
Щипцы для ананаса RLJLIVES из нержавеющей стали
82 ₽
Характеристики
Декстроза для картофеля агар Петри бактериальная чаша грибов проект
Описание товара
Трекер стоимости
Отзывы покупателей
Новые отзывы о товарах
Григорий Гаврилович Исаакян 11 Февраля 2022, 10:52 #
ОЧЕНЬ ПЛОХОЙ ПРОДАВЕЦ, НЕ ПОКУПАЙТЕ У НЕГО НИ ЧЕГО . Я С ДУРУ ЗАКАЗАЛ У НЕГО НОЖЬ , ТЕПЕРЬ У... Читать отзыв полностью...
ВЛАДИМИР 15 Апреля 2022, 08:19 #
Не прислали товар,вышли все сроки и обманули с возвратом денег.Аферисты,не связывайтесь с ними....... Читать отзыв полностью...
Александр Ибрагимов 28 Декабря 2022, 16:51 #
Эта очень хитрая воровка Не связывайтесь Товар получите не тот что заказывали Или брак-востановлению не подлежит Спор открыть она вам... Читать отзыв полностью...
спчрчыспр 30 Января 2022, 15:29 #
немного глупый вид.Некачественные швы портят весь вид... Читать отзыв полностью...

Настроил все 16 спутников. Работает прекрасно! Две головы ловят сразу по два спутника. А вот можно ли подключить дополнительно DS-C... Читать отзыв полностью...